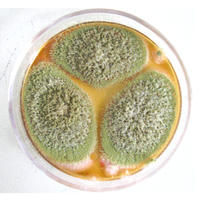
寄生麴黴

形態特徵
寄生麴黴
寄生麴黴分生孢子梗單生,不分枝,末端擴展成具有1-2列小梗的頂囊,小梗上有成串的3.6-6μm球形分生孢子。分生孢子梗長300-700μm,延伸向頭狀物方向,擴寬到10-14μm。頂囊直徑16-25μm。培養物淺黃綠色。子囊階段不明顯。
寄生於多種同翅目,鱗翅目,膜翅目昆蟲。感染寄生麴黴的昆蟲,體表起初長有白色菌絲,後布滿黃綠色菌絲及其孢子。
盤點麴黴屬及其相關有性型的真菌
| 麴黴屬是叢梗孢目(Moniliales)叢梗孢科中的一屬。在自然界分布極廣,是引起多種物質霉腐的主要微生物之一。本期主要是盤點該屬及其相關。 |
